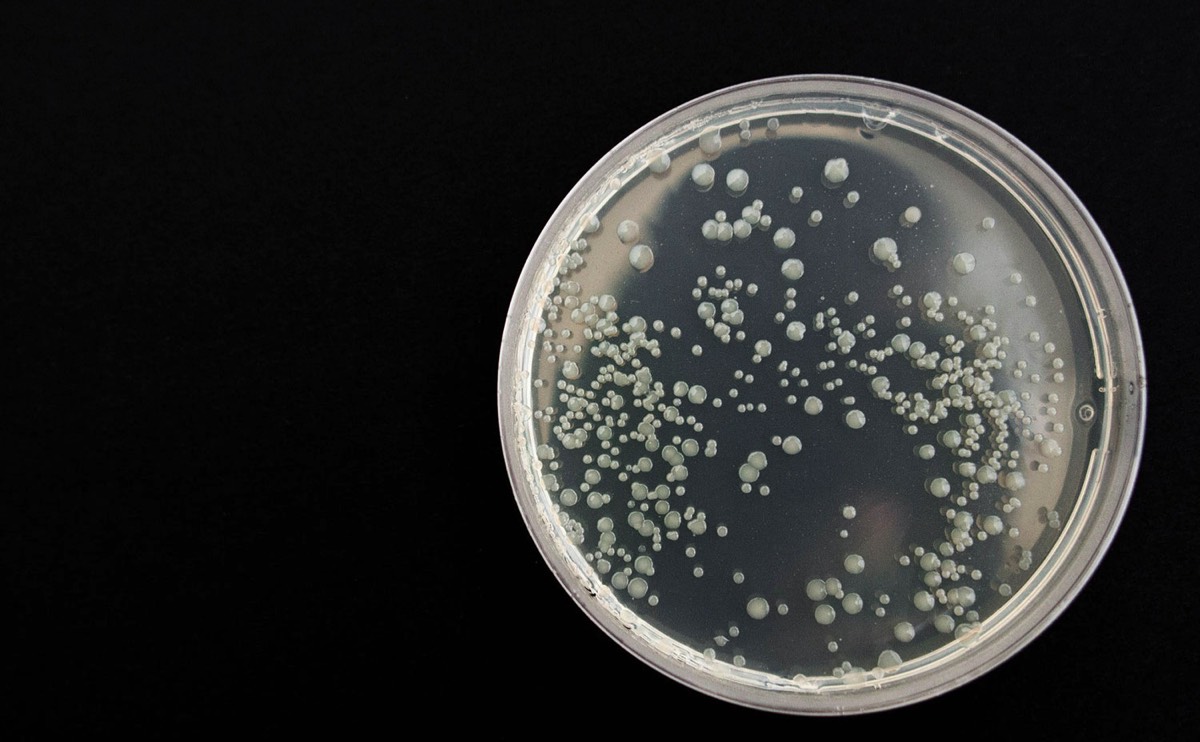
agar plate

Biology 190
Introduction to Cell and Molecular Biology
Add Background Images Here

Biology 190 Laboratory
In the event of an emergency and you need to switch sections for a week, this is a list of all the laboratory sections and the instructors. You must receive permission before attending a different section.
Laboratory Documents

If I am your laboratory instructor then the following documents apply to you.
If you registered with a different laboratory instructor please refer to that instructor for all laboratory matters.
Links to the lab manual are found here.
If you registered with a different laboratory instructor please refer to that instructor for all laboratory matters.
Links to the lab manual are found here.
This document is subject to change with advance notice or due to errors.
All BIOL 190 students will write a literature review paper covering a recent, original scientific finding in biology.






